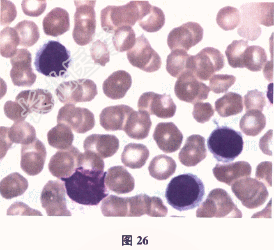

试题详情
- [材料题] 患者男性,50岁,发现脾大2个月,脾大平脐。既往有疟疾病史。查血常规:Hb 131g/L,WBC 7.92×109/L,PLT 52×109/L。近期出现低热,多出现在下午,最高37.6℃。
- 多项选择题1.根据患者血象及临床特征,考虑的诊断有
A、肝硬化
B、脾功能亢进
C、急性白血病
D、慢性淋巴细胞白血病
E、淋巴瘤
F、骨髓增殖性肿瘤
关注下方微信公众号,搜题查看答案

- 多项选择题2.【提示】进一步检查血细胞分类形态,提示外周血淋巴细胞比例78%, 多数为小一中淋巴细胞,部分有细胞的毛刺样突起, 染色质比正常淋巴细胞略疏松,浆灰蓝或深蓝色, 有的有泡沫感(图26)。患者的诊断可能是
A、肝硬化
B、病毒感染
C、慢性淋巴细胞白血病
D、成人T淋巴细胞白血病
E、毛细胞白血病
F、脾脏边缘区B淋巴细胞白血病
G、骨髓增殖性肿瘤
关注下方微信公众号,搜题查看答案

- 多项选择题3.【提示】患者骨髓细胞形态学:淋巴细胞比例、形态与外周血基本相似, 骨髓活检显示小淋巴细胞呈结节状或弥漫性大片增生,细胞质略丰富, 之间相连形成似陷窝样结构。免疫表型:淋巴细胞增高, 表达CD20、CD22、CD11c、CD103、CD25、CD123、FMN7,不表达CD3、CD5、CD10。该患者的诊断是
A、病毒感染
B、慢性淋巴细胞白血病
C、毛细胞白血病
D、脾边缘区B淋巴细胞白血病
E、成人T淋巴细胞白血病
F、骨髓增殖性肿瘤
关注下方微信公众号,搜题查看答案

- 多项选择题4.患者被确诊为毛细胞白血病,该类疾病血液分析仪散点图的特点是
A、淋巴细胞群增多,并出现高强度侧向荧光信号的细胞群向上延伸
B、在幼稚细胞群区细胞增多
C、中性粒细胞细胞群细胞增多
D、细胞三点基本集中于淋巴细胞核单核细胞区域。形成一个宽大集落无法分类
E、嗜酸性粒细胞区域显示细胞减少
F、单核细胞区域显示细胞增多
关注下方微信公众号,搜题查看答案

热门试题
- 一种好的血小板稀释液应具备哪些条件A、能
- 下列叙述中,正确的是A、巨幼红细胞增多见
- 关于蚕豆病,下列说法符合的是A、血清结合
- 有关浆细胞白血病描述正确的是A、继发性浆
- 以下关于红细胞沉降率说法正确的有A、血沉
- 1、该患者的贫血属于2、该患者最可能的诊
- 下列哪几项是血小板活化的分子标志物A、β
- 符合急性白血病完全缓解标准的有A、临床无
- 下列有关急性红白血病的说法正确的是A、外
- 1、判断是否贫血,通常依据哪几项参数A、
- 凝血酶的主要作用是:A、使纤维蛋白原裂解
- 1、考虑患者可能发生下列哪一类型的输血反
- 下列哪些说法符合恶性淋巴瘤A、外周血白细
- 血液内磷浓度受哪些因素的影响( )。A
- 合格的HiCN转化液必须具备的指标是A、
- 嗜碱性点彩红细胞检测常用的染色方法为A、
- 红细胞异常结构,下列哪些机制不正确A、卡
- 1、患者最可能的诊断为A、MMB、AML
- 1、计算结果正确的是A、MCV=92.2
- 1、下面哪项不正确A、核实患者身份B、核